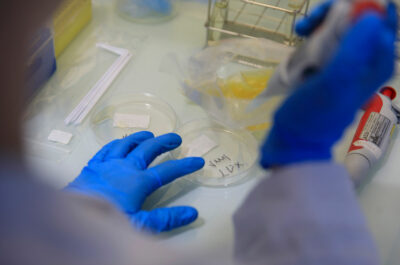

Estimados clientes: Nos complace informarles que Biolinea ofrece análisis para la detección del coronavirus SARS-CoV-2 (COVID-19) en superficies. Los ensayos se ejecutan mediante la detección de RNA por RT-PCR, realizados por técnicos y equipos cualificados. Los análisis son fiables y la toma de muestra es sencilla y segura. Los resultados pueden estar disponibles en un plazo de 3 días desde la toma de la muestra. Según los diferentes estudios, el coronavirus SARS-CoV-2 puede sobrevivir desde pocas horas hasta varios días en algunas superficies, siendo por tanto la limpieza y desinfección fundamentales para su control. Los análisis, junto con otras herramientas, pueden ser una herramienta eficaz para mejorar la bioseguridad, al verificar que la limpieza y la desinfección se han realizado de la manera adecuada. Estos análisis pueden ser realizados en hoteles, restaurantes, residencias geriátricas, hospitales, spas, colegios, gimnasios, comercios, supermercados, clínicas, peluquerías y gabinetes de estética y otros establecimientos públicos con elevado trasiego de personal. Biolinea le facilitará todo el asesoramiento técnico necesario sobre estos análisis, la toma de muestras y la interpretación de los resultados para su mejor comprensión y aplicación práctica.